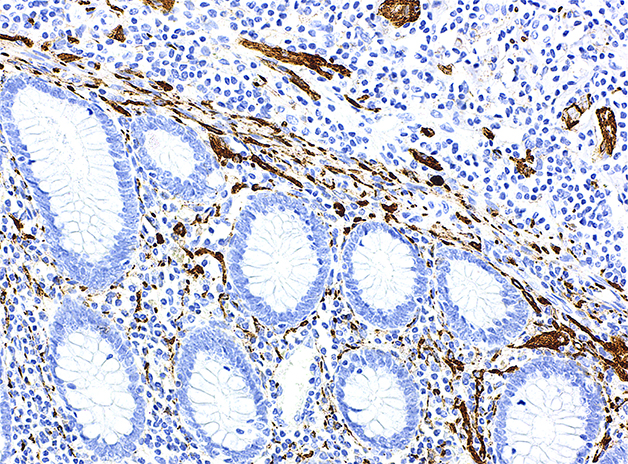

产品名称: CD56抗体试剂(免疫组织化学)
克隆号: ATO-013
种属来源: 兔单抗
细胞定位: 细胞膜/细胞质
阳性对照: 扁桃体/阑尾
修复方式: EDTA热处理
型号/规格: 工作液(3mL、6mL、9mL、12mL、15mL)
在线咨询
CD56为神经细胞粘附分子(Neural Cell Adhesion Molecule,NCAM),是一种膜糖蛋白。CD56表达于神经内分泌细胞、神经细胞、NK细胞和部分活化的T淋巴细胞、卵巢间质细胞、子宫平滑肌细胞以及成骨细胞中;甲状腺滤泡上皮、肝细胞和肾小管也可见表达。肿瘤主要表达于神经内分泌肿瘤和NK细胞淋巴瘤,但肝细胞癌、甲状腺乳头状癌、甲状腺滤泡癌、胶质瘤、骨髓瘤、卵巢性索间质肿瘤和视网膜母细胞瘤也可见阳性。
主要用于肺小细胞癌和神经内分泌肿瘤的诊断。
备案凭证
苏苏械备20211170号
在线询价
继续深入了解此产品,你可以在此提交你的需求